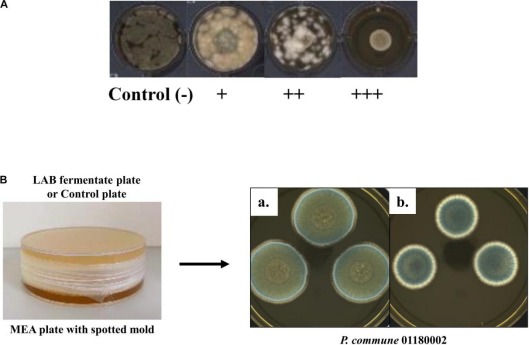
image.png

品质至上,客户至上,您的满意就是我们的目标
技术文章
当前位置: 首页 > 技术文章
歌本哈根大学利用Videometerlab发表奶制品腐败相关真菌研究的文章
发表时间:2021-07-22 16:47:33点击:1068
来源:北京博普特科技有限公司
分享:
最近,来自丹麦歌本哈根的科学家利用Videometer多光谱成像系统发表了题为Sensitivity of Molds From Spoiled Dairy Products Towards Bioprotective Lactic Acid Bacteria Culture,文章发表于知名期刊Front. Microbiol.,https://doi.org/10.3389/fmicb.2021.631730.北京博普特科技有限公司是丹麦Videometer公司系统多光谱成像系统中国区总代理,全面负责其系列产品在中国市场的推广、销售和售后服务。VideometerLab本身也是一款多光谱菌落表型成像和计数系统。
文中使用Videometer所做研究:
Multispectral images of plates with spotted molds were captured by a Videometer Lab2 spectral imaging instrument (Videometer ApS, Hørsholm,Denmark), and mold growth was expressed by the average size of three colonies in pixel units calculated according to Ebrahimi et al. (2015) using MATLAB 2018b software (MathWorks, inc., Natick, MA, United States)
Sensitivity of Molds From Spoiled Dairy Products Towards Bioprotective Lactic Acid Bacteria Cultures
Ce Shi* and Susanne Knøchel
Laboratory of Food Microbiology and Fermentation, Department of Food Science, University of Copenhagen, Copenhagen, Denmark
Fungal spoilage of dairy products is a major concern due to food waste and economical losses, some fungal metabolites may furthermore have adverse effects on human health. The use of lactic acid bacteria (LAB) is emerging as a potential clean label alternative to chemical preservatives. Here, our aim was to characterize the growth potential at three storage temperatures (5, 16, and 25°C) of a panel of molds (four Mucor and nine Penicillium strains) isolated from dairy products, then investigate the susceptibility of the molds toward 12 LAB cultures. Fungal cell growth and morphology in malt extract broth was monitored using oCelloScope at 25°C for 24 h. Mucor plumbeus 01180036 was the fastest growing and Penicillium roqueforti ISI4 (P. roqueforti ISI4) the slowest of the tested molds. On yogurt-agar plates, all molds grew at 5, 16, and 25°C in a temperature-dependent manner with Mucor strains growing faster than Penicillium strains regardless of temperature. The sensitivity toward 12 LAB cultures was tested using high-throughput overlay method and here all the molds except P. roqueforti ISI4 were strongly inhibited. The antifungal action of these LAB was confirmed when spotting mold spores on agar plates containing live cells of the LAB strains. However, if cells were removed from the fermentates, the inhibitory effects decreased markedly. The antifungal effects of volatiles tested in a plate-on-plate system without direct contact between mold and LAB culture media were modest. Some LAB binary combinations improved the antifungal activity against the growth of several molds beyond that of single cultures in yogurt serum. The role of competitive exclusion due to manganese depletion was examined as a possible antifungal mechanism for six Penicillium and two Mucor strains. It was shown that this mechanism was a major inhibition factor for the molds tested apart from the non-inhibited P. roqueforti ISI4 since addition of manganese with increasing concentrations of up to 0.1 mM resulted in partly or fully restored mold growth in yogurt. These findings help to understand the parameters influencing the mold spoilage of dairy products and the interactions between the contaminating strains, substrate, and bioprotective LAB cultures.